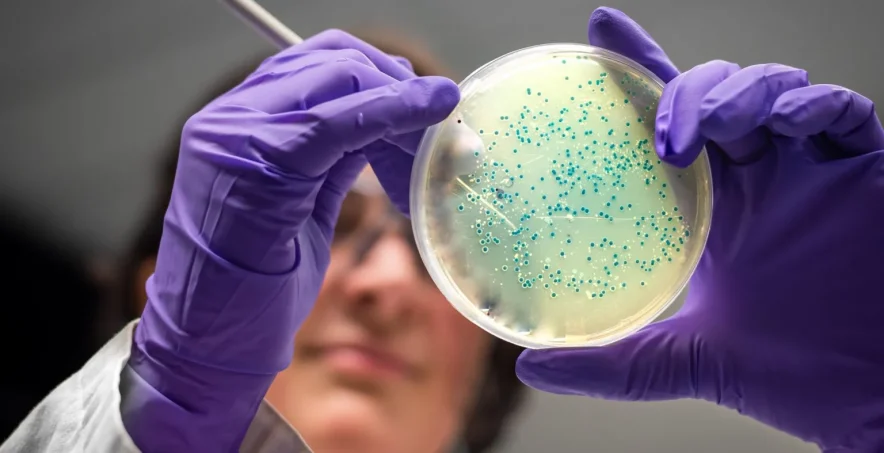

AI designs antibiotics for gonorrhoea and MRSA superbugs
Artificial intelligence has invented two new potential antibiotics that could kill drug-resistant gonorrhoea and MRSA, researchers have revealed.The drugs were designed atom-by-atom by the AI and killed the superbugs in laboratory and animal tests.
The two compounds still need years of refinement and clinical trials before they could be prescribed.
But the Massachusetts Institute of Technology (MIT) team behind it say AI could start a "second golden age" in antibiotic discovery.